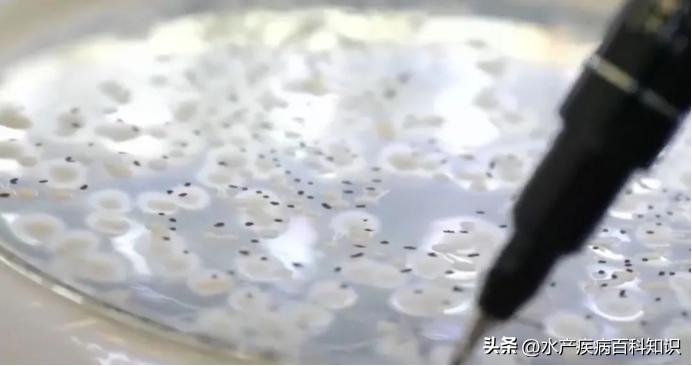
对虾肝肠孢虫脱离宿主能存活多久,一分钟带你了解对虾肝肠孢虫

最近很多养殖朋友反映,今年的虾特别难养,肝肠孢子虫特别多,很多养到1个月后,发现对虾慢料,加不起料,最典型的特点是对虾的大小参差不齐。拿虾来测一下肝肠孢虫106IU/g以上特别高,虾这么小卖没人要,排塘又舍不得,养又怕虾长不大,亏损更加严重,今天就跟大家分享一下肝肠孢虫新技术。
先跟大家分享一个案例反馈:
2022年7月,山东日照养殖对虾客户,发现对虾吃料慢,大小不齐,2022.8.8送样品到研究所检测,结果如下:

结果显示:EHP 1876000
收到结果后,客户使用了很多的治疗产品,皆效果不佳,徐老板咨询过后建议采用中药处理方案,使用 顽蟲净 拌料加内服 连用一个疗程,于2022.8.26再次送样检测,详细报告见下图:

检测结果显示,肠胞虫的数量220500,吃料正常,可以增强营养开始催肥。
肝肠孢子虫通常不会导致南美白对虾死亡,这很容易被养殖户朋友忽略。根据现有研究报告,肝肠孢虫与白便综合征之间也存在一定的相关性。同时,肝肠孢虫的检出率与南美白对虾生长的缓慢生长成正相关性。
对于虾肝肠孢子虫的诊断,首先要观察虾是否生长缓慢,以及同一池塘中是否有大小不同的虾。如果存在上述现象,需要通过实验室检测进一步确诊。由于肝肠孢子虫的体积较小,因此需要使用光学显微镜对其进行虫体的形态观察。
分析:虾肝肠孢虫一经发现,尽快处理。可采取纯中药发酵液 《顽蟲净》 :富含杨淑华、干姜、乌梅、南瓜子、使君子等多种名贵中药材,驱杀孢子虫、锚头鳋、小瓜虫、线虫、绦虫、斜管虫、车轮虫等体内外寄生虫;并且对水体无损害,无抗药性,无污染,使用过后更无需解毒、培藻培菌,即健康又安全。
最后提醒大家,肝肠孢虫以预防为主,治疗损失大,风险大。很多虾苗携带肝肠孢虫,要抓住黄金期的前40天,预防感染肝肠孢虫。